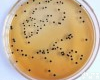
木糖赖氨酸去氧胆酸盐<em>琼脂</em><em>XLD</em><em>琼脂</em>

XLD 琼脂
- 产地:上海
- 供应商:上海瑞齐实验试剂有限公司
- 供应商报价:面议
- 标签:XLD 琼脂,1,上海瑞齐实验试剂有限公司
产品名称:XLD 琼脂
规格:250g/瓶
使用范围:仅供科研使用
库存:提供现货(因销量问题库存会有变动,具体请与销售人员确认)
保存:低温避光保存
XLD 琼脂 的步骤:
(一)准确称量试剂:根据不同的菌类和用途,选择适宜的培养基,培养基所需试剂必须纯净。(二)校正pH值:将称量好的培养基各种成分放入容器内,标记划线,加热溶解,补充水分,测定酸碱度,常用pH6.8~8.0的精密试纸或酸度计测定。用1N NaOH和1N HCl调节pH值到适宜范围内。(三)过滤:将玻璃漏斗置铁架上,再用纱布夹棉花或用滤纸放在漏斗中,将上述培养基倒入其中过滤至透明。
(四)分装:将过滤后的培养基分装于中试管或三角瓶内(试管内每支装5mL;三角瓶中装100~150ml),塞好棉塞用牛皮纸包扎好,准备灭菌。
(五)灭菌:培养基的灭菌,常用高压蒸汽灭菌法。一般微生物的营养细胞在水中煮沸后即被杀死,但细菌的芽胞有较强的抗热性,须经高压蒸汽灭菌才能达到彻底灭菌的目的。根据蒸汽温度随压力升高而上升的原理,即压力越大,蒸汽温度就越高。因此,在同一温度条件下,采用高压蒸汽灭菌比干热灭菌法效果要好。而且在湿热情况下,菌体吸收水分后,其蛋白质易于凝固变性,因为蒸汽的穿透力强,杀菌效果好。
GFAP 小鼠神经胶质纤维酸性蛋白 上海直销 规格: 48T/96T
ENA-78/CXCL5 小鼠上皮中性粒细胞活化肽78 说明书 规格: 48T/96T
PEDF 小鼠色素上皮衍生因子 供应 规格: 48T/96T
T3 小鼠三碘甲状腺原氨酸 价格 规格: 48T/96T
MMTV 小鼠乳腺肿瘤病毒 上海直销 规格: 48T/96T
小鼠乳腺癌标志物-CA153ELISA Kit,48T/96T 小鼠乳腺癌标志物-CA153ELISA Kit,48T/96T 说明书 规格: 48T/96T
LF/LTF 小鼠乳铁传递蛋白/乳铁蛋白 供应 规格: 48T/96T
LZM 小鼠溶菌酶 价格 规格: 48T/96T
β-CG 小鼠绒毛膜促性腺激素β 上海直销 规格: 48T/96T
CG 小鼠绒毛膜促性腺激素 说明书 规格: 48T/96T
PAPP-A 小鼠妊娠相关血浆蛋白A 供应 规格: 48T/96T
HSF1 小鼠热休克因子1 价格 规格: 48T/96T
HSP gp96 小鼠热休克蛋白糖蛋白96 上海直销 规格: 48T/96T
HSP-90 小鼠热休克蛋白90 说明书 规格: 48T/96T
HSP-70 小鼠热休克蛋白70 供应 规格: 48T/96T
Hsp-60 小鼠热休克蛋白60 价格 规格: 48T/96T
Hsp-40 小鼠热休克蛋白40 上海直销 规格: 48T/96T
HSP-27 小鼠热休克蛋白27 说明书 规格: 48T/96T
Hsp-20 小鼠热休克蛋白20 供应 规格: 48T/96T
IMA 小鼠缺血修饰白蛋白 价格 规格: 48T/96T
ALD 小鼠醛固酮 上海直销 规格: 48T/96T
i-PTH 小鼠全段甲状旁腺素 说明书 规格: 48T/96T
NA 小鼠去甲肾上腺素 供应 规格: 48T/96T
FK 小鼠趋化因子 价格 规格: 48T/96T
Hyp 小鼠羟脯氨酸 上海直销 规格: 48T/96T
Pro-ANP 小鼠前心钠肽 说明书 规格: 48T/96T
氯化钠结晶紫增菌液Pro-ANP 小鼠前心钠肽 供应 规格: 48T/96T
PSA 小鼠前列腺特异性抗原 价格 规格: 48T/96T
PAP 小鼠前列腺酸性磷酸酶 上海直销 规格: 48T/96T
PGF 小鼠前列腺素F 说明书 规格: 48T/96T
PGE2 小鼠前列腺素E2 供应 规格: 48T/96T
公司专业供应的培养基, 现货直销,质量有保障,款到当天可发货,免费快递送货上门,欢迎新老顾客订购!氯化钠结晶紫增菌液缩短细胞培养周期,降低生产成本,超越竞争对手。培养基的配方还有很多,它们可根据研究对象的特点或研究者的要求而制定。故在培养基的配方中常可见到有的提高了某种成份,有的又降低了某种成份。
贮存:培养基在30℃下放置一天,无污染的即可使用。一般用牛皮纸包裹好存放于2-8℃冰箱中备用。
氯化钠结晶紫增菌液的应用在微生物培养方面越来越广泛,我们深知培养基配置养料稍有偏差直接影响微生物的成长,公司销售的培养基均提供权威的质量检测报告。随着时间的推移,我司可提供多种规格、不同品Pai的培养基。
公司提供多达千余种微生物培养基配方、原理、用法、质量控制,涵盖所有常检细菌及其他细菌,涉及食品卫生检验、医药、水质、临床、化妆品等各个领域、为您提供Z详尽的微生物培养基相关知识。根据不同的菌类和用途,选择适宜的培养基,培养基所需试剂必须纯净。
培养基配置原则:
1、选择适宜的营养物质。
2、营养物质浓度及配比合适。
3、控制pH条件。
4、控制氧化还原电位(redox potential)。
5、原料来源的选择。
6、灭菌处理注:本产品只可用于科研实验,不能用于临床应用。
系列产品:
70801-15 非酶DNA清除剂-2 15 次1290
70803-100 单菌落质粒筛选试剂盒100 次1290
70804-50 单菌落质粒DNAout 50 次1290
70901-50 柱式真菌DNAout 50 次1590
70902-1.5 PCR级甜菜碱溶液1.5 mL 1190
70903-50 一步式质粒DNAout 2.0 50 次1290
70904-1.5 酵母tRNA溶液1.5 mL 1120
70905-1.5 PCR级明胶溶液1.5 mL 2190
70906-0.5 NTP溶液0.5 mL 2190
70907-100 去离子甲酰胺100 mL 2120
70908-100 PAGE DNAback 100 次2350
70908-30 PAGE DNAback 30 次1120
71001-50 柱式病毒RNAout 50 次2990
71002-100 凝固血液DNAout 100 次2990
71002-30 凝固血液DNAout 30 次2490
71101-5 一步式大提质粒DNAout 5 次2490
71201-50 柱式动物RNAout 50 次2490